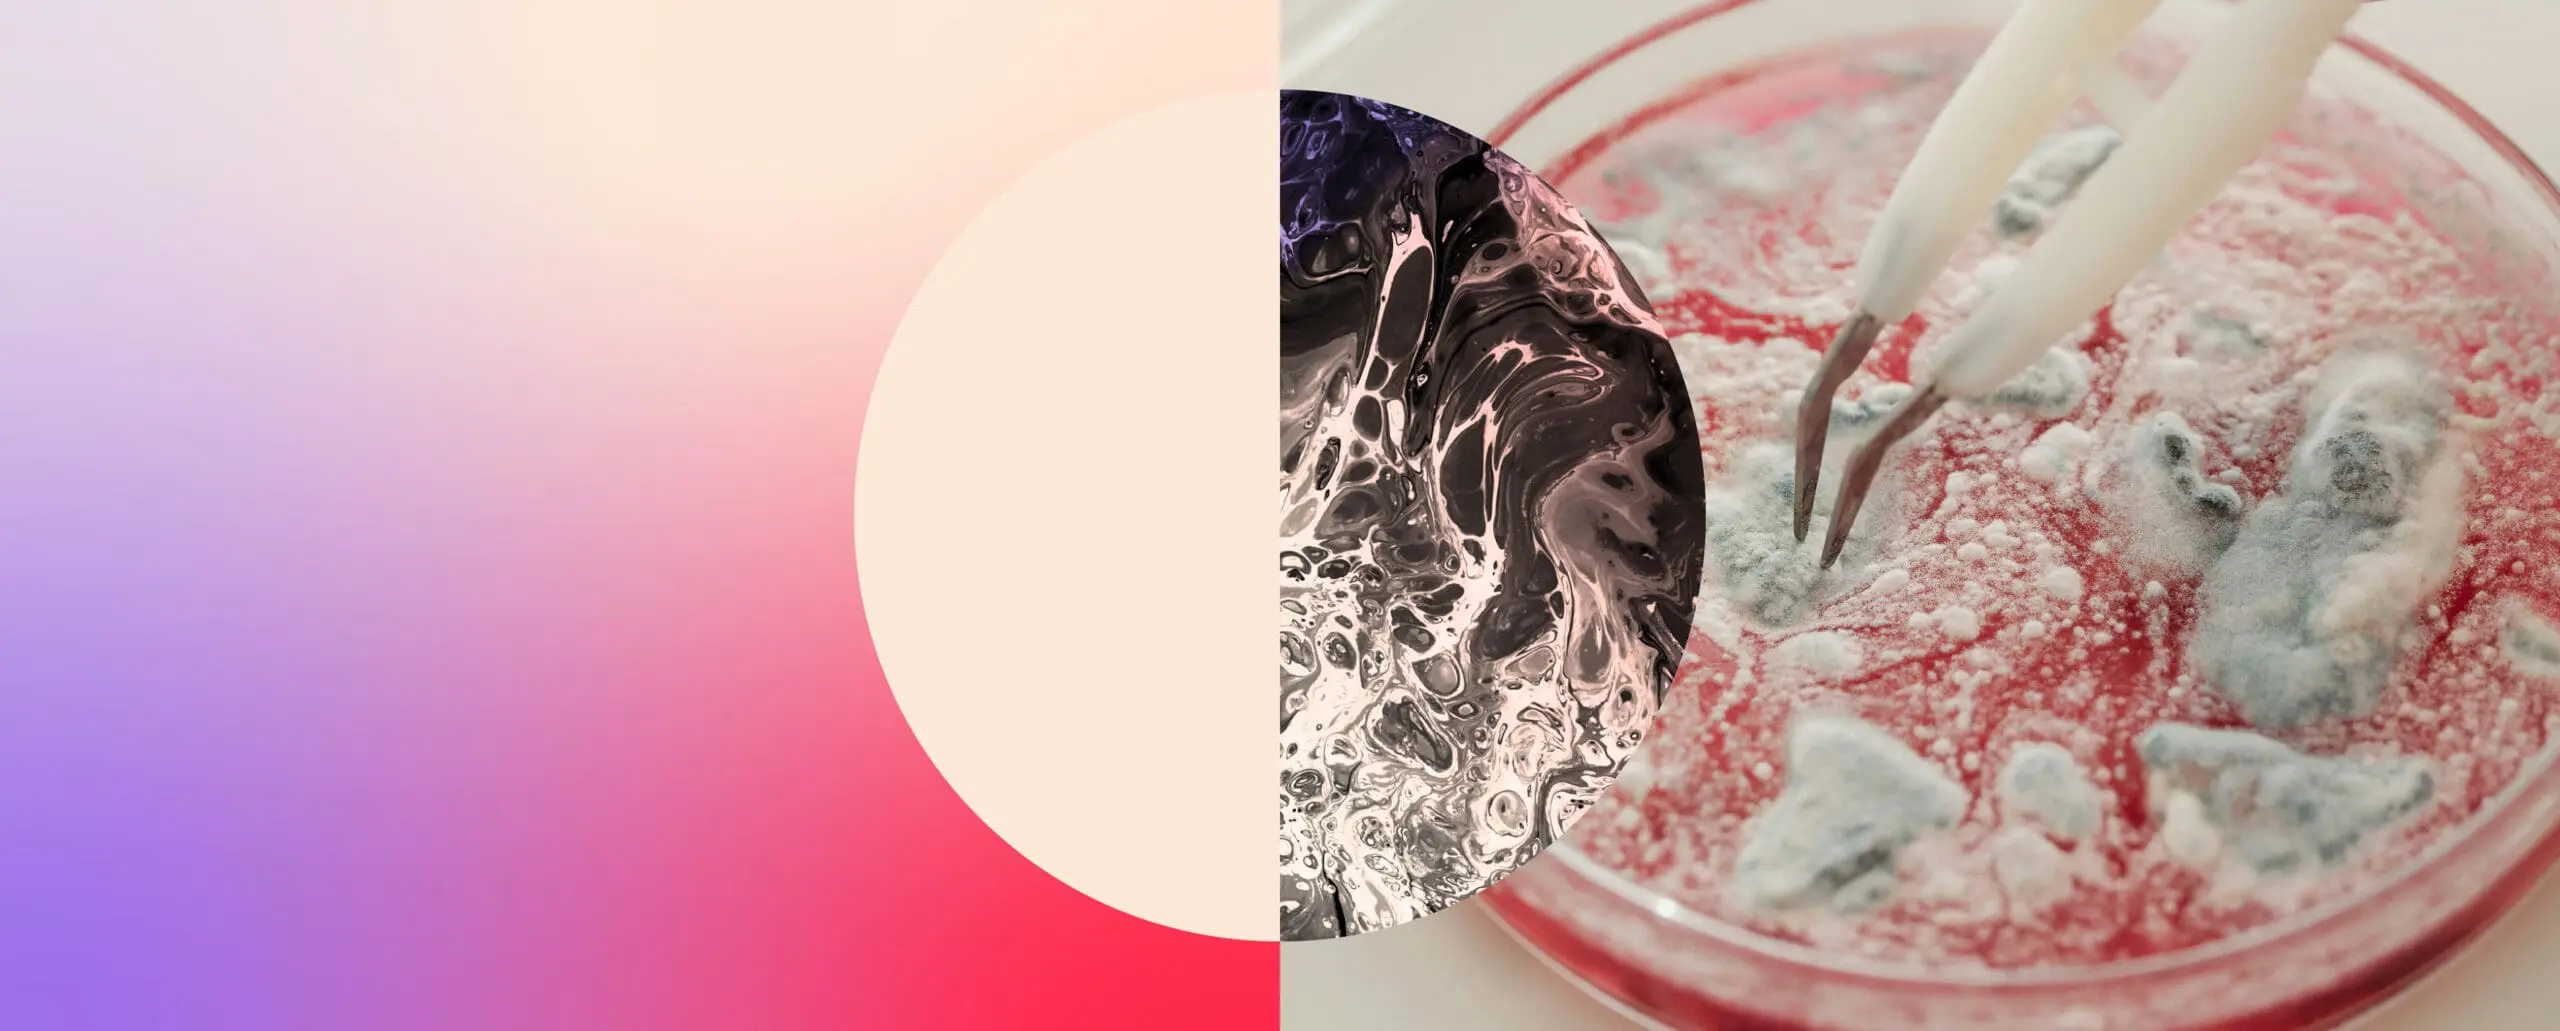

Because top talent chooses more than just a job – they choose a story they believe in.
In today’s competitive life sciences market, the war for talent isn’t won on job boards. It’s won through reputation, clarity of purpose, and a strong employer brand. For pharmaceutical, biotech, MedTech and healthcare organisations, your ability to attract the best candidates hinges on how you’re perceived as an employer.
Your employer brand is the way candidates view your organisation as a place to work. It’s shaped by your mission, your culture, your leadership, and how consistently you deliver on your promises – both during the hiring process and long after someone joins your team.
In candidate-short markets like life sciences, this perception can make or break your ability to attract top-tier professionals.
Why employer branding matters more than ever in life sciences hiring
The best candidates – whether regulatory leaders, R&D scientists or commercial innovators -aren’t typically active jobseekers. They’re passive. Selective. And they’re paying close attention to how companies show up.
Strong employer branding builds trust before the first conversation even happens. It turns cold outreach into warm engagement, and it influences how a candidate feels about your organisation before they read a job spec.
A well-crafted employer brand gives candidates a reason to choose you – not just for what you offer, but for what you stand for.
A strong employer brand helps you:
- Attract higher-calibre candidates – particularly those who aren’t actively job hunting
- Shorten time-to-hire – by creating early alignment between candidate and company
- Increase offer acceptance – when candidates already believe in your mission and values
- Drive diversity and inclusion – by communicating a culture where all backgrounds are welcomed
- Improve long-term retention – by setting clear, realistic expectations from the outset
In short, your brand becomes your advantage – helping you attract, engage and retain talent who will thrive in your environment.
What life sciences professionals want to know before they apply
In industries where purpose matters, candidates want clarity and authenticity. They want to know:
- What impact your work has – on science, patients, or public health
- How you support learning, development, and internal progression
- What your company culture is like day-to-day – not just what’s written on a website
- Whether their values align with yours – especially around ethics, sustainability, and inclusion
This isn’t about slogans or perks. It’s about telling the real story of your organisation – and delivering on it.
How Axion builds employer branding into every search
At Axion, we see every role as more than a vacancy – it’s a chance to tell your story to the people who matter most. That’s why we don’t just promote roles – we position them within a bigger narrative: your mission, your values, and your culture.
We advise on messaging, tone, candidate experience, and market positioning – because how you hire is just as important as who you hire. And when your employer brand resonates with the right people, everything else follows.